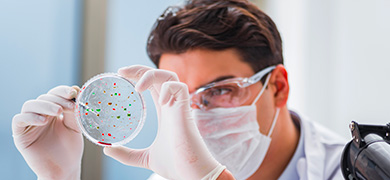
Témoignage M2i Life Sciences

découvrez les témoignages d'entreprise
Les entreprises qui nous ont fait confiance souhaitent vous partager leur expérience

Découvrez tous les témoignages

Biose
Une PME Auvergnate, leader mondial du marché des produits biothérapeutiques vivants

La Foir’Fouille
Tendances, maillage territorial : voir plus grand pour rester le leader du discount de la maison

Picture Organic Clothing
Un engagement bio et éthique pour un succès international
Besoin d’en savoir plus ?
Votre chargé d’affaires est à votre disposition pour vous accompagner.
Prendre rendez-vous